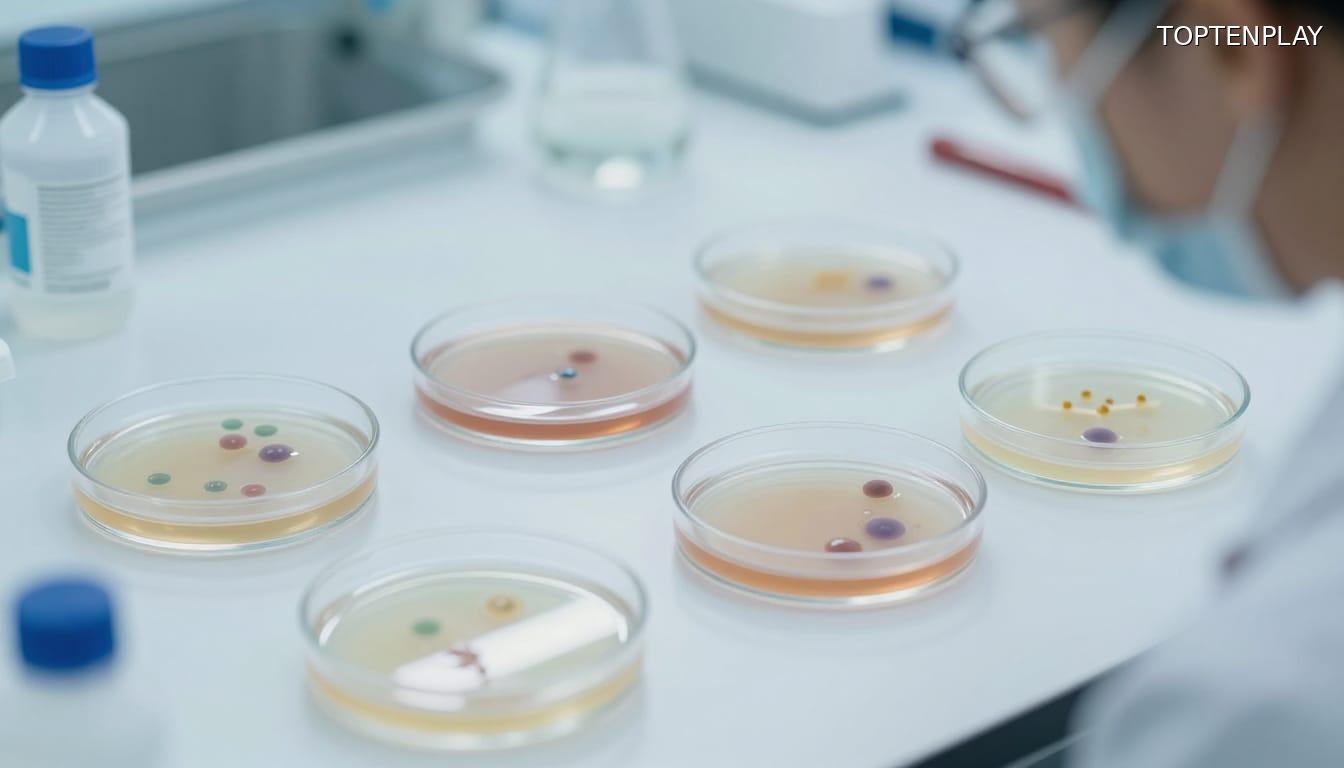
Image d'illustration © TopTenPlay

📌 Lidl rappelle d’urgence du poulet Saint-Alby : les lots précis contaminés aux salmonelles

Posted 20 mars 2026 by: Admin

Alerte Sanitaire : Lidl Rappelle Des Blancs De Poulet Contaminés
Une contamination aux salmonelles vient de déclencher une procédure de rappel d’urgence chez Lidl. L’enseigne allemande retire de la vente des blancs de poulet de la marque Saint-Alby, commercialisés ces derniers jours dans de nombreux magasins français. Le produit incriminé, baptisé « 100 % filet, doré au four, cuit à l’étouffée », se présentait sous forme de barquettes sous vide contenant 4 tranches pour un poids total de 160 grammes.
La présence de bactéries potentiellement dangereuses impose une consigne absolue : ne pas consommer ce produit. Les clients doivent vérifier immédiatement leurs réfrigérateurs et identifier les lots à risque. Tous les articles dont le numéro de lot commence par 2611316, portant le code-barres 4056489513261, doivent être détruits ou rapportés en magasin. L’enseigne s’engage à rembourser intégralement les achats concernés, sans exiger de justificatif.
Cette alerte sanitaire survient après la détection de salmonelles lors des contrôles qualité. L’annonce officielle, diffusée mercredi sur la plateforme gouvernementale Rappel Conso, cible spécifiquement une distribution géographique limitée mais étendue. Les consommateurs des régions du sud et de l’ouest de la France sont particulièrement concernés par cette procédure d’urgence, qui s’inscrit dans un délai de commercialisation précis et circonscrit.

Périmètre Du Rappel : 31 Départements Du Sud Et De L’Ouest Touchés
Cette distribution géographique délimitée couvre 31 départements français, concentrés dans trois grandes régions. La zone Provence-Alpes-Côte d’Azur figure en première ligne avec les Alpes-de-Haute-Provence, les Hautes-Alpes, les Alpes-Maritimes, les Bouches-du-Rhône, le Var et le Vaucluse. L’Occitanie compte également de nombreux territoires concernés : Ardèche, Ariège, Aude, Aveyron, Gard, Haute-Garonne, Gers, Hérault, Lot, Tarn, Tarn-et-Garonne et Hautes-Pyrénées. La Nouvelle-Aquitaine complète cette cartographie avec la Charente, la Charente-Maritime, la Corrèze, la Creuse, la Dordogne, la Gironde, les Landes, le Lot-et-Garonne, les Pyrénées-Atlantiques, les Deux-Sèvres et la Haute-Vienne. Le Cantal et la Drôme s’ajoutent à cette liste.
La fenêtre de commercialisation s’étend du 13 au 17 mars 2026, soit une période de cinq jours seulement. Cette distribution éclair explique la concentration géographique du rappel et la nécessité d’une réaction rapide des consommateurs. Les acheteurs de ces départements doivent impérativement consulter la plateforme Rappel Conso pour identifier les magasins précis ayant vendu le produit contaminé. Cette liste exhaustive des points de vente permet de cibler avec précision les foyers d’exposition au risque.
L’identification des lots demeure l’élément déterminant pour évaluer le danger réel encouru par les consommateurs de ces territoires.

Symptômes Et Délais : Ce Qu’Il Faut Surveiller Après Consommation
L’identification des lots constitue la première étape, mais la surveillance médicale détermine la réponse appropriée en cas d’exposition. Les toxi-infections provoquées par les salmonelles se manifestent par des troubles gastro-intestinaux d’apparition brutale : diarrhées et vomissements surviennent généralement accompagnés de fièvre et de maux de tête. La temporalité joue un rôle crucial dans le diagnostic : ces symptômes apparaissent entre 6 et 72 heures après la consommation du produit contaminé.
Cette fenêtre de trois jours définit la période critique pendant laquelle les consommateurs doivent rester vigilants. Selon les recommandations sanitaires, toute personne présentant ces manifestations après avoir mangé le poulet rappelé doit contacter son médecin sans délai. La fiche de rappel précise toutefois qu’une absence de symptômes après sept jours écarte tout risque d’infection, rendant la consultation médicale inutile passé ce délai.
La rapidité d’apparition des troubles distingue la salmonellose d’autres intoxications alimentaires. Les six premières heures restent rarement concernées, mais la période comprise entre 24 et 72 heures concentre la majorité des cas déclarés. Cette caractéristique temporelle aide les professionnels de santé à orienter leur diagnostic et justifie l’urgence du rappel lancé par Lidl.
La gravité de ces infections varie considérablement selon les populations exposées, certains profils présentant des vulnérabilités particulières face à cette bactérie.
Contexte Épidémiologique : Une Infection Courante Mais À Ne Pas Négliger
Les vulnérabilités individuelles trouvent leur explication dans la prévalence même de cette bactérie. La salmonellose représente la deuxième cause d’infection gastro-intestinale chez l’être humain en Europe, juste après la campylobactériose, selon l’Institut Pasteur. Les estimations françaises recensent entre 100.000 et 200.000 cas annuels, faisant de cette contamination une réalité sanitaire majeure malgré sa faible médiatisation.
Cette fréquence élevée contraste avec un pronostic généralement favorable : la maladie se résout spontanément en quelques jours, avec ou sans traitement médical. Les organismes sains éliminent naturellement la bactérie, expliquant pourquoi la majorité des infections passent inaperçues ou restent bénignes. Cette guérison spontanée ne doit toutefois pas masquer les dangers réels pour certaines catégories de population.
Les femmes enceintes et les patients immunodéprimés font face à des risques significativement accrus. Leur système immunitaire affaibli ou modifié ne parvient pas toujours à contenir l’infection, qui peut alors évoluer vers des complications graves. Les statistiques nationales comptabilisent entre 50 et 100 décès annuels imputables à la salmonellose, confirmant que cette pathologie courante reste potentiellement mortelle.
Cette dualité entre banalité épidémiologique et gravité potentielle justifie la réactivité des autorités sanitaires lors de chaque rappel, transformant une contamination limitée en alerte nationale prioritaire.




















